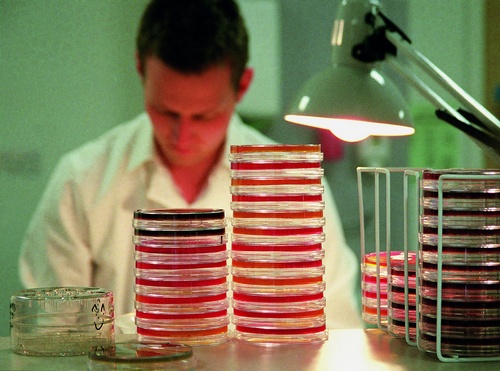

Číslo 1 - 2 / 2016
Specifika perioperační péče o pacienty s methicilin rezistentním Staphylococcem aureem
Stafylokokové infekce patří mezi významné bakteriální vyvolavatele nozokomiálních infekcí. Nozokomiální nákazy jsou nežádoucí komplikací zdravotní péče a mají řadu negativních důsledků, jako je nárůst mortality, morbidity a zhoršení kvality života pacientů. Způsobují hlavně prodloužení délky hospitalizace a vzestup nákladů na zdravotní péči. Ve zdravotnických zařízeních představují tyto infekce zásadní problém, protože vytvářejí rezistenci na jakékoliv častěji používané antibiotikum.
Hlavním představitelem tohoto rodu je Staphylococcus aureus. V roce 1960 se začal používat jako antibiotikum methicilin. První rezistentní stafylokokové kmeny byly zaznamenány v roce 1961 a byly označovány jako MRSA (methicilin rezistentní Staphylococcus aureus). V České republice byl v roce 2004 zaznamenán vyšší nárůst této infekce, se kterou se častěji setkáváme i na operačních sálech a její výskyt nezadržitelně stoupá. Proto je velmi důležité dodržovat zásady asepse, dezinfekce a sterilizace a zabránit šíření těchto nákaz. V nemocničních zařízeních existují standardní ošetřovatelské postupy u pacientů s diagnózou MRSA, které jsou orientovány především na lůžková oddělení, ale neobsahují konkrétní postupy pro operační sál. V rámci perioperační prevence infekcí je důležité, aby sestry perioperační péče znaly a dodržovaly standardní postupy při ošetřování pacienta s MRSA.
Právě to, zda sestry perioperační péče znají specifika péče o pacienty s MRSA na operačním sále a zda dodržují bariérové postupy u pacientů s MRSA, bylo cílem našeho šetření, které se uskutečnilo mezi 50 sestrami perioperační péče.
Metodika
K výzkumu jsme použily kvantitativní metodu anonymního dotazníkového šetření. Dotazník se skládal z 27 uzavřených otázek. První část dotazníku obsahovala identifikační otázky, druhá část otázky znalostní a otázky v třetí části dotazníku se týkaly specifických postupů při ošetřování pacientů s MRSA na operačním sále a jejich dodržování. Vyhodnoceno bylo 50 dotazníků. K výběru souboru jsme použily záměrný výběr s jedním kritériem. Výzkumný soubor tvořily sestry perioperační péče.
Diskuze
Průzkum byl zaměřen na perioperační péči u pacientů s MRSA. Oslovily jsme sestry perioperační péče pracující na sálech různého typu. Na začátku dotazníkového šetření byly pokládány identifikační otázky. 70 % dotazovaných sester pracuje na sále více než 10 let. Nejvíce zastoupená věková skupina respondentů byla 36–45 let a druhá 46–55 let.
Další část dotazníkového šetření byla zaměřena na znalosti perioperačních sester o specifikách péče u pacientů s MRSA na operačním sále. MRSA je označení pro methicilin rezistentní Staphylococcus aureus (Beneš, 2009). 72 % dotázaných sester vědělo přesný název této zkratky. 22 % dotázaných sester označilo tuto zkratku za multirezistentní, což je nesprávné. Je důležité, aby sestry znaly informace o MRSA, protože 86 % dotázaných sester uvedlo, že se s pacientem s MRSA setkaly ve své praxi. Do znalostního testu jsme zařadily otázku, vůči jakým druhům antibiotik je MRSA rezistentní. Správnou odpověď zvolilo 62 % dotázaných sester. Třetina respondentů se domnívala, že je rezistentní na všechna antibiotika. Jak uvádí Beneš (2009), MRSA je rezistentní na antibiotika z řady penicilinů a cefalosporinů. Dále jsme zjišťovaly, kde dotazované sestry získaly informace o specifikách péče o pacientech s MRSA. 42 % dotazovaných sester získalo informace na seminářích celoživotního vzdělávání. Z odborných publikací získalo informace o MRSA 28 % dotázaných a 22 % respondentů získalo informace v rámci výuky. Dle Kalábové (2008) byl od roku 2004 v České republice zaznamenán vyšší nárůst MRSA, a proto se s ním budeme setkávat častěji i na operačních sálech. Z výše uvedeného můžeme říci, že sestry znají specifika perioperační péče o pacienty s MRSA.
Předcházení vzniku a šíření nemocničních nákaz u pacientů je základním předpokladem úspěšné práce každého operačního týmu (Duda, 2000). Proto je zásadní, aby sestry perioperační péče znaly základy protiepidemických opatření. 86 % dotazovaných sester uvedlo, že bylo proškoleno v protiepidemických opatřeních. Z toho 20 respondentů bylo proškoleno zaměstnavatelem a tři respondenti byli proškoleni v rámci pomaturitního specializačního studia. Je alarmující, že 14 % dotazovaných sester uvedlo, že nebyly proškoleny nikdy. MRSA je, jak uvádí Beneš (2009), typická nozokomiální nákaza. Proto jsme další část dotazníku zaměřily na znalost sester o nozokomiálních nákazách. Nejčastějším zdrojem nozokomiálních nákaz je zdravotnický personál. Tuto správnou odpověď označilo 76 % dotazovaných sester. 60 % respondentů uvedlo, že nejčastější cestou přenosu jsou ruce zdravotníka, 20 % označilo kapénkovou infekci a 20 % označilo oděv. Maďar (2006) uvádí, že k přenosu infekce dochází přímou cestou, kontaktem vnímavého jedince s nemocnou osobou. Mezi nepřímé cesty přenosu patří kontakt jedince s infikovanými předměty.
Protože zdravotníci jsou nejčastějším zdrojem nozokomiálních nákaz, je podstatné, aby sestry protiepidemická opatření znaly a mohly je aplikovat do praxe. Proti vzniku nozokomiální nákazy je nutno dodržovat bariérovou ošetřovatelskou péči. Mezi bariérová opatření na operačním traktu spadá respektování ochranných zón. Do ochranné zóny spadají pobytové místnosti, toalety, sklad a úklidové místnosti. Většina sester označila pobytové místnosti, ale toalety označila méně než polovina dotázaných sester. Sklad označilo 66 % respondentů a úklidové místnosti pouze 48 % respondentů. Chybnou odpověď, že do ochranné zóny patří umývárna operačního sálu, označilo 40 % respondentů. Do aseptické zóny spadají umývárna operačního sálu a vlastní operační sál. Přestože výzkumný soubor tvořily perioperační sestry, umývárnu označilo pouze 60 % dotazovaných sester a vlastní operační sál označilo 68 % dotazovaných sester.
Očekávaly jsme vyšší četnost správných odpovědí. Aby sestry mohly provádět protiepidemická opatření, musejí být informovány o infekčním agens u pacienta. Je alarmující, že 54 % respondentů uvedlo, že jsou informováni pouze někdy. Vždy informováno o infekčním agens u pacienta je 46 % respondentů. Příznivým zjištěním je, že všechny dotazované sestry uvedly, že u plánovaných operačních výkonů je pacient s MRSA zařazen jako poslední výkon v operačním programu. 68 % dotazovaných sester ví, že cesta přenosu MRSA v ráně na operačním sále je rukama personálu, ale pouze 14 % respondentů ví, že cesta přenosu je i kontaminovaným prádlem. Informace o MRSA sestry získávají na seminářích a v odborných publikacích, ale přestože 90 % dotázaných sester uvedlo, že na jejich pracovišti je standard „jak postupovat při ošetřování MRSA“, jako zdroj informací o MRSA ho uvedlo jen 6 % dotázaných sester. Pozitivním zjištěním je, že 88 % dotázaných sester odpovědělo, že mají dostatek pomůcek, aby mohly specificky ošetřit pacienty s MRSA.
Staphylococcus aureus může způsobit řadu závažných onemocnění až po celkovou sepsi. Stafylokoková sepse s rozvojem celkových příznaků představuje život ohrožující stav (Beneš, 2009). Z našeho výzkumného vzorku jen 20 % dotazovaných sester uvedlo, že má strach ošetřovat pacienty s MRSA. Ostatních 80 % dotazovaných sester uvedlo, že strach při ošetřování pacientů s MRSA nemají.
Závěrečná část dotazníku byla věnována specifickým postupům u pacientů s MRSA, kteří podstupují operační výkon, a jejich dodržování. Úklid operačního sálu se provádí před a po každé operaci na vlhko s použitím běžných čisticích prostředků a dezinfekčních prostředků s virucidním účinkem. U operace pacientů s MRSA se používají prostředky cílené proti MRSA – tuto odpověď označilo pouze 22 % dotázaných sester. 90 % dotázaných sester vědělo, že po operaci pacienta s MRSA se provádí specifický úklid sálu. Z průzkumu vyplývá, že všichni respondenti vědí, že u plánovaných operačních výkonů jde pacient s MRSA jako poslední. Je překvapivé, že toto specifikum v otázce 20 označilo pouze 88 % dotázaných sester. Využití specifického oděvu pro operační tým při operaci pacienta s MRSA využívá pouze 26 % dotázaných sester. Využití specifického oděvu pro operační tým závisí na zvyklosti pracoviště. 52 % dotázaných sester uvádí, že dekontaminace operačních nástrojů a pomůcek přímo na operačním sále patří do specifik ošetřování pacientů s MRSA. Na operačních sálech vzniká specifický zdravotnický odpad, který má dle vyhlášky MZČR č. 306/2012 Sb. povahu nebezpečného odpadu a musí být označen a uložen v uzavíratelných a odolných obalech. 62 % respondentů označilo, že mezi specifika ošetřování pacienta s MRSA patří specifické třídění odpadu. Mezi specifické ošetřování pacienta s MRSA nepatří ochranné pomůcky pro pacienta. Tuto chybnou odpověď označilo 28 % dotázaných sester.
Maďar (2006) uvádí, že dezinfekce je soubor opatření k zneškodňování mikroorganismů, která mají přerušit cestu nákazy od zdroje k vnímavému jedinci. Správný postup při dezinfekci používaných pomůcek u pacientů s MRSA je ponoření pomůcek a nástrojů do dezinfekčního roztoku, následuje mechanická očista a vyšší stupeň dezinfekce či sterilizace. Tuto správnou odpověď zvolilo 74 % perioperačních sester. Chybu ve správném pořadí dezinfekčních postupů uvedlo 26 % dotázaných sester. Ustanovení § 56 vyhlášky č. 55/2011 Sb. definuje kompetence sestry pro perioperační péči. Sestra perioperační péče bez odborného dohledu provádí specializované sterilizační a dezinfekční postupy. Proto je zásadní, aby sestry perioperační péče tyto postupy znaly. 26 % chybných odpovědí je nevyhovující.
Bariérová ošetřovatelská péče je definována jako systém pracovních a organizačních opatření, která mají zabránit vzniku a šíření nozokomiálních nákaz. Tuto správnou odpověď označilo 90 % dotázaných sester a 10 % dotázaných sester označilo chybnou odpověď. Mezi bariérové postupy, které se používají u pacientů s MRSA na operačním sále, patří ochrana personálu, hygienické a mechanické mytí rukou, aseptické postupy, dezinfekce, sterilizace, vyšší stupeň dezinfekce, úklid a izolace. 92 % dotázaných sester označilo správnou odpověď a 8 % dotázaných sester označilo bariérové postupy chybně. Dle metodického návodu na mytí a dezinfekci rukou Ministerstva zdravotnictví ČR (2005) jsou přesně definovány dílčí postupy na mytí a dezinfekci rukou při ošetřovatelské péči o pacienty. K hygienickému mytí rukou se používá dezinfekční mýdlo nejméně po dobu 15–30 sekund. Tuto správnou odpověď uvedlo 64 % dotazovaných sester. Celkem 84 % dotazovaných sester uvedlo, že k chirurgické dezinfekci rukou se používá antiseptický roztok 3–5 ml nejméně po dobu 2 minut. Rukama zdravotníků je přeneseno více než 60 % nozokomiálních nákaz, proto je alarmující, že 16 % dotazovaných sester, které jsou specialistkami na perioperační péči, uvedlo chybnou odpověď. Prevenci infekcí v místě chirurgického výkonu ovlivňuje organizace operačních sálů, úroveň operačních postupů, ale hlavně správný a svědomitý aseptický přístup (Maďar, 2006). Proto je důležité, aby byl operační sál co nejvíce uzavřen. K tomu přispívá i spolupráce s ostatními členy operačního týmu a dodržování protiepidemického režimu. Všechny dotazované sestry uvedly, že je důležitá spolupráce s ostatními členy operačního týmu, jako je lékař, anesteziolog, sanitář, uklízečka a podobně. 98 % dotazovaných sester se domnívá, že dodržují osobní hygienu podle epidemiologického režimu.
jako MRSA (methicilin rezistentní Staphylococcus aureus)
foto: Profimedia
Na základě analýzy této části můžeme potvrdit, že sestry dodržují bariérové postupy u pacientů s MRSA.
Závěr
Toto průzkumné šetření bylo orientováno na problematiku specifik perioperační péče u pacientů s MRSA. Cílem průzkumu bylo zjistit, zda sestry perioperační péče znají specifika péče o pacienty s MRSA na operačním sále, a zjistit, zda sestry perioperační péče bariérové postupy u pacientů s MRSA dodržují.
Výsledky analýzy výzkumu nám potvrdily, že sestry znají specifika perioperační péče o pacienty s MRSA. Více než polovina dotázaných sester správně vysvětlila zkratku MRSA, věděla správnou odpověď týkající se rezistence na ATB a všichni dotazovaní věděli, že pacient s MRSA je zařazen do operačního programu jako poslední. Sestry dodržují bariérové postupy u pacientů s MRSA, znají a dodržují správný postup dezinfekce, třídí infekční odpad a provádějí správný úklid operačního sálu. Jelikož výzkumný soubor tvořily pouze sestry perioperační péče, očekávaly jsme vyšší četnost správných odpovědí v oblasti operačních zón a dezinfekce rukou.
V rámci perioperační prevence infekcí je důležité znát standardní postupy při ošetřování pacientů s MRSA; perioperační sestry by měly znát a hlavně dodržovat tyto postupy. Proto navrhujeme proškolení pracovníků v oblastech bariérové péče o pacienty s MRSA.
Bc. Jana Ježková, Mgr. Helena Michálková, Ph.D., Katedra ošetřovatelství a porodní asistence, Zdravotně sociální fakulta, Jihočeská univerzita v Českých Budějovicích
Další články v tomto čísle
- Stydlivě tajeným otcem pokroku je génius lidské lenosti (Gabriel Laub)
- Odkaz „starých dobrých zdrávek“…nejednotný názor, či nepochopení?
- Sestry – manažerky: péče o podřízené a jejich rozvoj
- Dětská otolaryngologie
- Výchova ke zdraví
- Jak na strach a úzkost v těhotenství
- Klinické doporučené postupy v ošetřovatelství
- Péče o pacienta s klostridiovou kolitidou
- Problematika hygienické péče u obézních pacientů
- Dezinfekce endoskopických přístrojů











